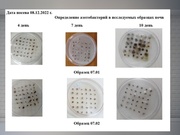
следующая страница →

Файл:Носова НБ МБОУ лицей №3.pdf
Перейти к навигации
Перейти к поиску
 Размер этого JPG-превью для исходного PDF-файла: 800 × 600 пикселей. Другое разрешение: 320 × 240 пикселей. |
Исходный файл (1500 × 1125 пикселей, размер файла: 1,91 МБ, MIME-тип: application/pdf, 11 страниц)
История файла
Нажмите на дату/время, чтобы просмотреть, как тогда выглядел файл.
| Дата/время | Миниатюра | Размеры | Участник | Примечание | |
|---|---|---|---|---|---|
| текущий | 15:40, 16 февраля 2023 |  | 1500 × 1125, 11 страниц (1,91 МБ) | Соболева Светлана Владимировна (обсуждение | вклад) |
- Вы не можете перезаписать этот файл.
Использование файла
Следующая 1 страница использует данный файл: